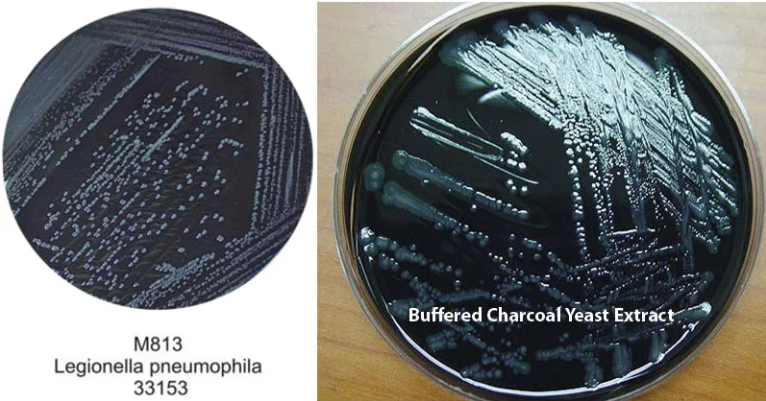
BCYE培养基

BCYE琼脂:成分、原理、制备、结果与应用
来源:武汉市灰藻生物科技有限公司 浏览量:148 发布时间:2026-03-30 15:51:07
引言
军团菌是一种在自然界中广泛存在的,水源性条件致病菌,当其通过人工水系统(如冷却塔、淋浴设施等)形成气溶胶,并被人体吸入后,可能引发两种临床结局:
一种是自限性的流感样疾病——庞蒂亚克热,另一种则是病情严重、死亡率可高达10%-15%的急性肺炎——军团病。
自1976年美国费城,首次爆发军团病以来,如何从复杂的环境样本和临床标本中,准确分离这一病原体,一直是微生物学诊断的核心挑战。
军团菌的培养条件极为苛刻,常规培养基无法满足其生长需求。正是在这一背景下,经过Feeley、Pasculle、Edelstein等多位学者持续改良,
BCYE(缓冲活性炭酵母浸膏,Buffered Charcoal Yeast Extract)琼脂应运而生,并在此后数十年间成为军团菌分离培养的“金标准”培养基。
本文将系统阐述BCYE琼脂的发展历程、成分原理、制备方法及结果判读,为从事微生物检验和公共卫生监测的专业人员提供参考。
历史沿革与发展
1978年,Feeley及其同事为了分离军团菌属(Legionella)细菌,首次开发出一种基础培养基。
随后,该培养基经过改良,用酵母浸膏取代了原来的酪蛋白水解物和牛肉浸膏,并用活性炭替代了淀粉,由此诞生了活性炭酵母浸膏(CYE)琼脂。
1980年,Pasculle等人进一步优化,在配方中添加了ACES(N-2-乙酰氨基-2-氨基乙磺酸)缓冲液,以维持最适生长的pH值,这种改进型培养基被正式命名为缓冲活性炭酵母浸膏(BCYE)琼脂。
1981年,Edelstein等研究者又引入α-酮戊二酸钾盐,这一举措显著提升了培养基的敏感性。如今,BCYE培养基被广泛推荐用于从水样及其他可能含有军团菌的样本中培养和初步分离该菌。
图1、BCYE琼脂平板
BCYE琼脂的成分
下表列出了BCYE琼脂的经典配方:
| 成分 | 含量(克/升) |
|---|---|
| 酵母浸膏 | 10.0 |
| ACES缓冲液 | 10.0 |
| 活性炭 | 2.0 |
| 氢氧化钾 | 2.8 |
| α-酮戊二酸 | 1.0 |
| L-半胱氨酸 | 0.4 |
| 焦磷酸铁 | 0.25 |
| 琼脂 | 12.0 |
最终pH值(25℃下)为 6.9±0.2
注:为提升选择性,可在基础培养基中无菌添加万古霉素、多粘菌素B、茴香霉素等抗生素组合,制成选择性BCYE琼脂,以抑制杂菌生长。
BCYE琼脂的原理
军团菌属细菌是不形成芽孢的革兰氏阴性细杆菌,可引起军团病(一种肺炎)或庞蒂亚克热。
这类细菌无法在常规培养基中氧化或发酵碳水化合物,也无法在绵羊血琼脂平板上生长。相比之下,它们在BCYE琼脂上的生长更为旺盛且快速。BCYE培养基的独特配方正是为了满足军团菌苛刻的生长需求:
• 氨基酸:氨基酸是军团菌的主要能量来源。其中,L-半胱氨酸是军团菌生长代谢中绝对必需的物质,因其自身无法合成,必须从外界摄取。
• 铁源:焦磷酸铁提供了细菌生长所需的铁离子,它和L-半胱氨酸共同协作,有力支持军团菌的生长。
• 解毒剂:活性炭在培养基中扮演着解毒剂的角色,它能分解对军团菌有毒的代谢产物——过氧化氢,同时可能有助于收集二氧化碳和调节表面张力,为细菌创造一个低毒的微环境。
• 营养基础:酵母浸膏富含维生素、氮源和碳源,为细菌生长提供全面的营养支持。
• pH缓冲:ACES缓冲液能将培养基的pH值稳定在最适范围(6.9±0.2),这对于军团菌的生长和关键成分(如L-半胱氨酸)的稳定至关重要。
• 生长刺激:α-酮戊二酸能通过刺激清除氧自由基的酶系统活性,从而促进军团菌的生长。
• 凝固剂:琼脂则作为培养基的凝固剂,为菌落的形成提供固体支撑。
BCYE琼脂的制备方法
1. 称量与溶解:称取20克脱水培养基粉末,悬浮于500毫升蒸馏水中。
2. 加热煮沸:加热并煮沸,使培养基完全溶解。
3. 灭菌:将培养基置于高压灭菌锅中,在121℃(15磅压力)下灭菌15分钟。然后冷却至约50℃。
4. 添加补充剂:在无菌条件下,向冷却好的培养基中加入一支复溶后的军团菌生长补充剂(通常含有L-半胱氨酸和焦磷酸铁)。如果需要抑制杂菌,也可在此步加入相应的抗生素补充剂。
5. 混匀与倒板:充分混匀,并在不断搅拌下倾倒平板,以确保活性炭颗粒在琼脂中分布均匀。由于活性炭易沉淀,搅拌步骤尤为重要。
BCYE琼脂上的结果解读
在BCYE琼脂上,嗜肺军团菌(Legionella pneumophila)的典型菌落特征如下:
• 形态与颜色:菌落大小不一,可从微小到较大。通常光滑、无色至淡蓝灰色,略带粘液状。随着培养时间延长,菌落会变得更白,边缘可能出现丝状结构。
• 荧光特性:在长波紫外灯下观察,典型的军团菌菌落会发出黄绿色荧光,这一特征有助于初步鉴别。
• 表面结构:菌落表面通常光滑,边缘整齐。但某些菌株在显微镜下观察时,可能呈现毛玻璃样或类似“煎蛋”的形态。
BCYE琼脂的用途
• 分离与鉴定:主要用于从临床标本(如痰液、肺泡灌洗液)和环境样本(如冷却塔水、淋浴水)中分离和初步鉴定军团菌。
• 基础培养基:作为军团菌分离培养的基础培养基,为后续的生化、免疫或分子生物学鉴定提供纯培养物。
BCYE琼脂的局限性与注意事项
• 确证试验的必要性:在BCYE平板上生长的可疑菌落,必须通过生化试验、免疫学检测(如直接荧光抗体法)、分子生物学方法或质谱技术进行最终鉴定,以确保结果的准确性。
• 联合使用多种培养基:为提高分离成功率,建议同时使用非选择性和选择性BCYE琼脂平板进行平行接种。此外,也应考虑与其他培养基(如血平板)联合使用,以验证军团菌对L-半胱氨酸的依赖性(在缺乏L-半胱氨酸的培养基上不生长)。
• 菌株生长差异:由于营养需求的个体差异,少数军团菌菌株可能在该培养基上生长不良甚至完全不生长。
• 培养条件:美国疾病控制与预防中心(CDC)建议在含2.5% CO₂的环境下培养环境样本。目前已知,在这种条件下,戈氏军团菌(L. gormanii)的生长能得到增强,但并非所有菌种都必需。
• 背景颜色影响:如果使用白色背景的过滤膜进行培养,其上生长的菌落外观可能与在黑色或深色背景过滤膜上生长的菌落有所不同,判读时需注意。
• 生物安全:在处理疑似含有军团菌的培养物或样本时,必须严格遵守生物安全操作规程,采取有效措施防止产生气溶胶,以保障实验人员安全。
结语
BCYE琼脂的成功研制与应用,是微生物培养基发展史上的一项经典案例。从最初的基础CYE配方,到引入ACES缓冲液实现pH稳定,再到添加α-酮戊二酸提升培养敏感性,每一次改良都凝聚着研究者对军团菌生理代谢特征的深刻理解。正是这种基于微生物生长需求的精准设计,使得BCYE琼脂能够有效中和有毒代谢产物、提供必需氨基酸和铁源、维持适宜酸碱环境,从而为营养要求苛刻的军团菌创造出近乎理想的人工培养条件。值得注意的是,尽管BCYE琼脂是目前最常用的分离工具,但其应用仍需结合多个关键要点:确证试验不可省略,多种培养基应联合使用,操作过程须严防气溶胶形成。唯有将优质的培养基与规范的操作流程相结合,才能确保军团菌检测结果的准确可靠,为临床诊断、疫情溯源和公共卫生风险评估提供坚实的实验依据。
参考文献
https://microbenotes.com/buffered-charcoal-yeast-extract-bcye/
相关产品
敬请关注灰藻生物,共筑健康未来!
— 武汉市灰藻生物科技有限公司团队敬上
灰藻生物:我们期待着与客户共同成长,共创生命科学的美好未来!
更新日期:2026-03-28
编制人:冬冬
审稿人:小藻